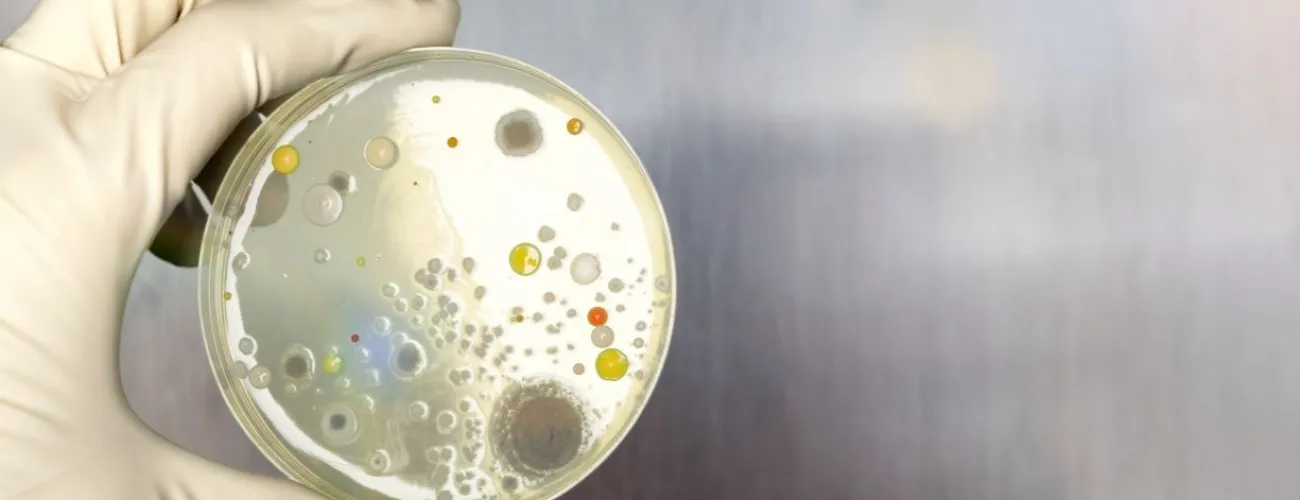
échantillon bactéries

Soins de santé
Depuis quelques décennies, les infections résistantes aux antibiotiques ne cessent d’augmenter et provoquent de nombreuses morts. Pour la première fois, une vaste étude menée dans plus de 200 pays est parvenue à chiffrer l’impact du phénomène.
Publié le: 26 janvier 2022
Par: Candice Leblanc
2 min
Photo: © AdobeStock
Depuis la découverte de la pénicilline, en 1928, les antibiotiques ont sauvé des millions de vies. Ces médicaments, dirigés contre les bactéries pathogènes pour l’être humain, ne sont toutefois pas infaillibles. Apparus sur Terre bien avant nous, ces microbes ont développé de remarquables capacités d’adaptation et de survie. Au cours du XXe siècle, chaque fois qu’un antibiotique a été mis sur le marché, il n’a fallu que quelques années, voire mois avant que n’émergent des bactéries résistant à ce traitement.
Depuis quelques décennies, cette antibiorésistance ne cesse d’augmenter. Traitées avec succès pendant longtemps, des bactéries comme E. coli ou les staphylocoques dorés ne réagissent quasiment plus aux antibiothérapies actuelles.
Pour la première fois, une vaste étude (1), menée dans plus de 200 pays, est parvenue à chiffrer l’impact du phénomène. En 2019, près de 5 millions de personnes seraient décédées dans un contexte d’infection “antibiorésistante” ; pour 1,27 million d’entre elles, ladite infection est la cause directe et établie du décès. Ce n’est qu’un début : selon l’OMS, à l’horizon 2050, ce seront 10 millions de personnes qui en mourront chaque année…
Comment contrer ce phénomène ? Selon les experts, il faut d’abord mieux utiliser les antibiotiques existants, notamment en ne les prescrivant que lorsqu’ils sont vraiment nécessaires et en encourageant les patients à prendre leur traitement jusqu’au bout. Ensuite, les infections potentiellement problématiques doivent être surveillées et contrôlées de plus près. Enfin et surtout, nous devons investir massivement dans la recherche scientifique afin de développer de nouveaux traitements contre les bactéries multirésistantes.
(1) "Global burden of bacterial antimicrobial resistance in 2019 : a systematic analysis", Murray C. et al., The Lancet, 19 janvier 2022